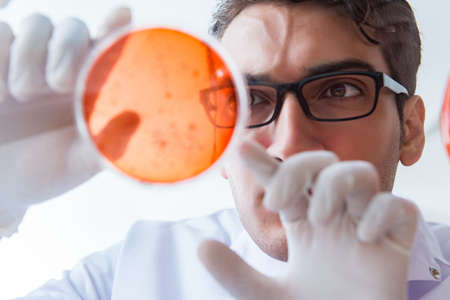
Chemist working in the laboratory with hazardous chemicalsの写真素材

写真素材 - Chemist working in the laboratory with hazardous chemicals
キーワード
- analyzing
- beaker
- biochemistry
- biology
- biotechnology
- capsules
- chemical
- chemistry
- clinic
- clinical
- doctor
- drugs
- education
- equipment
- examining
- experiment
- forensic
- glass
- glassware
- health
- healthcare
- hospital
- lab
- laboratory
- man
- medical
- medicine
- medicines
- microbe
- microbiology
- microscope
- pharmaceutical
- pharmacist
- pharmacology
- pharmacy
- pills
- research
- researcher
- sample
- science
- scientific
- scientist
- student
- syringe
- tablets
- technician
- test
- tube
- tubing
- chemist
類似作品
chemical in gla...
Medical researc...
BEIJING, CHINA ...
Doctor in prote...
Bottles with ch...
BEIJING, CHINA ...
Close-up scient...
old laboratory ...
COVID-19 or SAR...
flammable chemi...
COVID-19 and me...
Medical scienti...
Researchers wor...
Medical researc...
Erlenmeyer Flas...
researchers wor...
Drugs, person a...
BEIJING, CHINA ...
Science glasswa...
Researchers wor...
Laboratory test...
Coronavirus cov...
container with ...
Corona virus co...
the doctor hold...
Chemical contai...
Team of scienti...
Researchers wor...
Chemistry profe...
Dangerous reage...
Development che...
Health care res...
Young male rese...
Female research...
BEIJING, CHINA ...
chemical glass ...
Researchers wor...
Researchers wor...
Chemical, foren...
BEIJING, CHINA ...
BEIJING, CHINA ...
Close up of Asi...
Experiments in ...
Various medicin...
Ecologist in pr...
COVID-19 and me...
BEIJING, CHINA ...
white lab mouse...
COVID-19 or SAR...